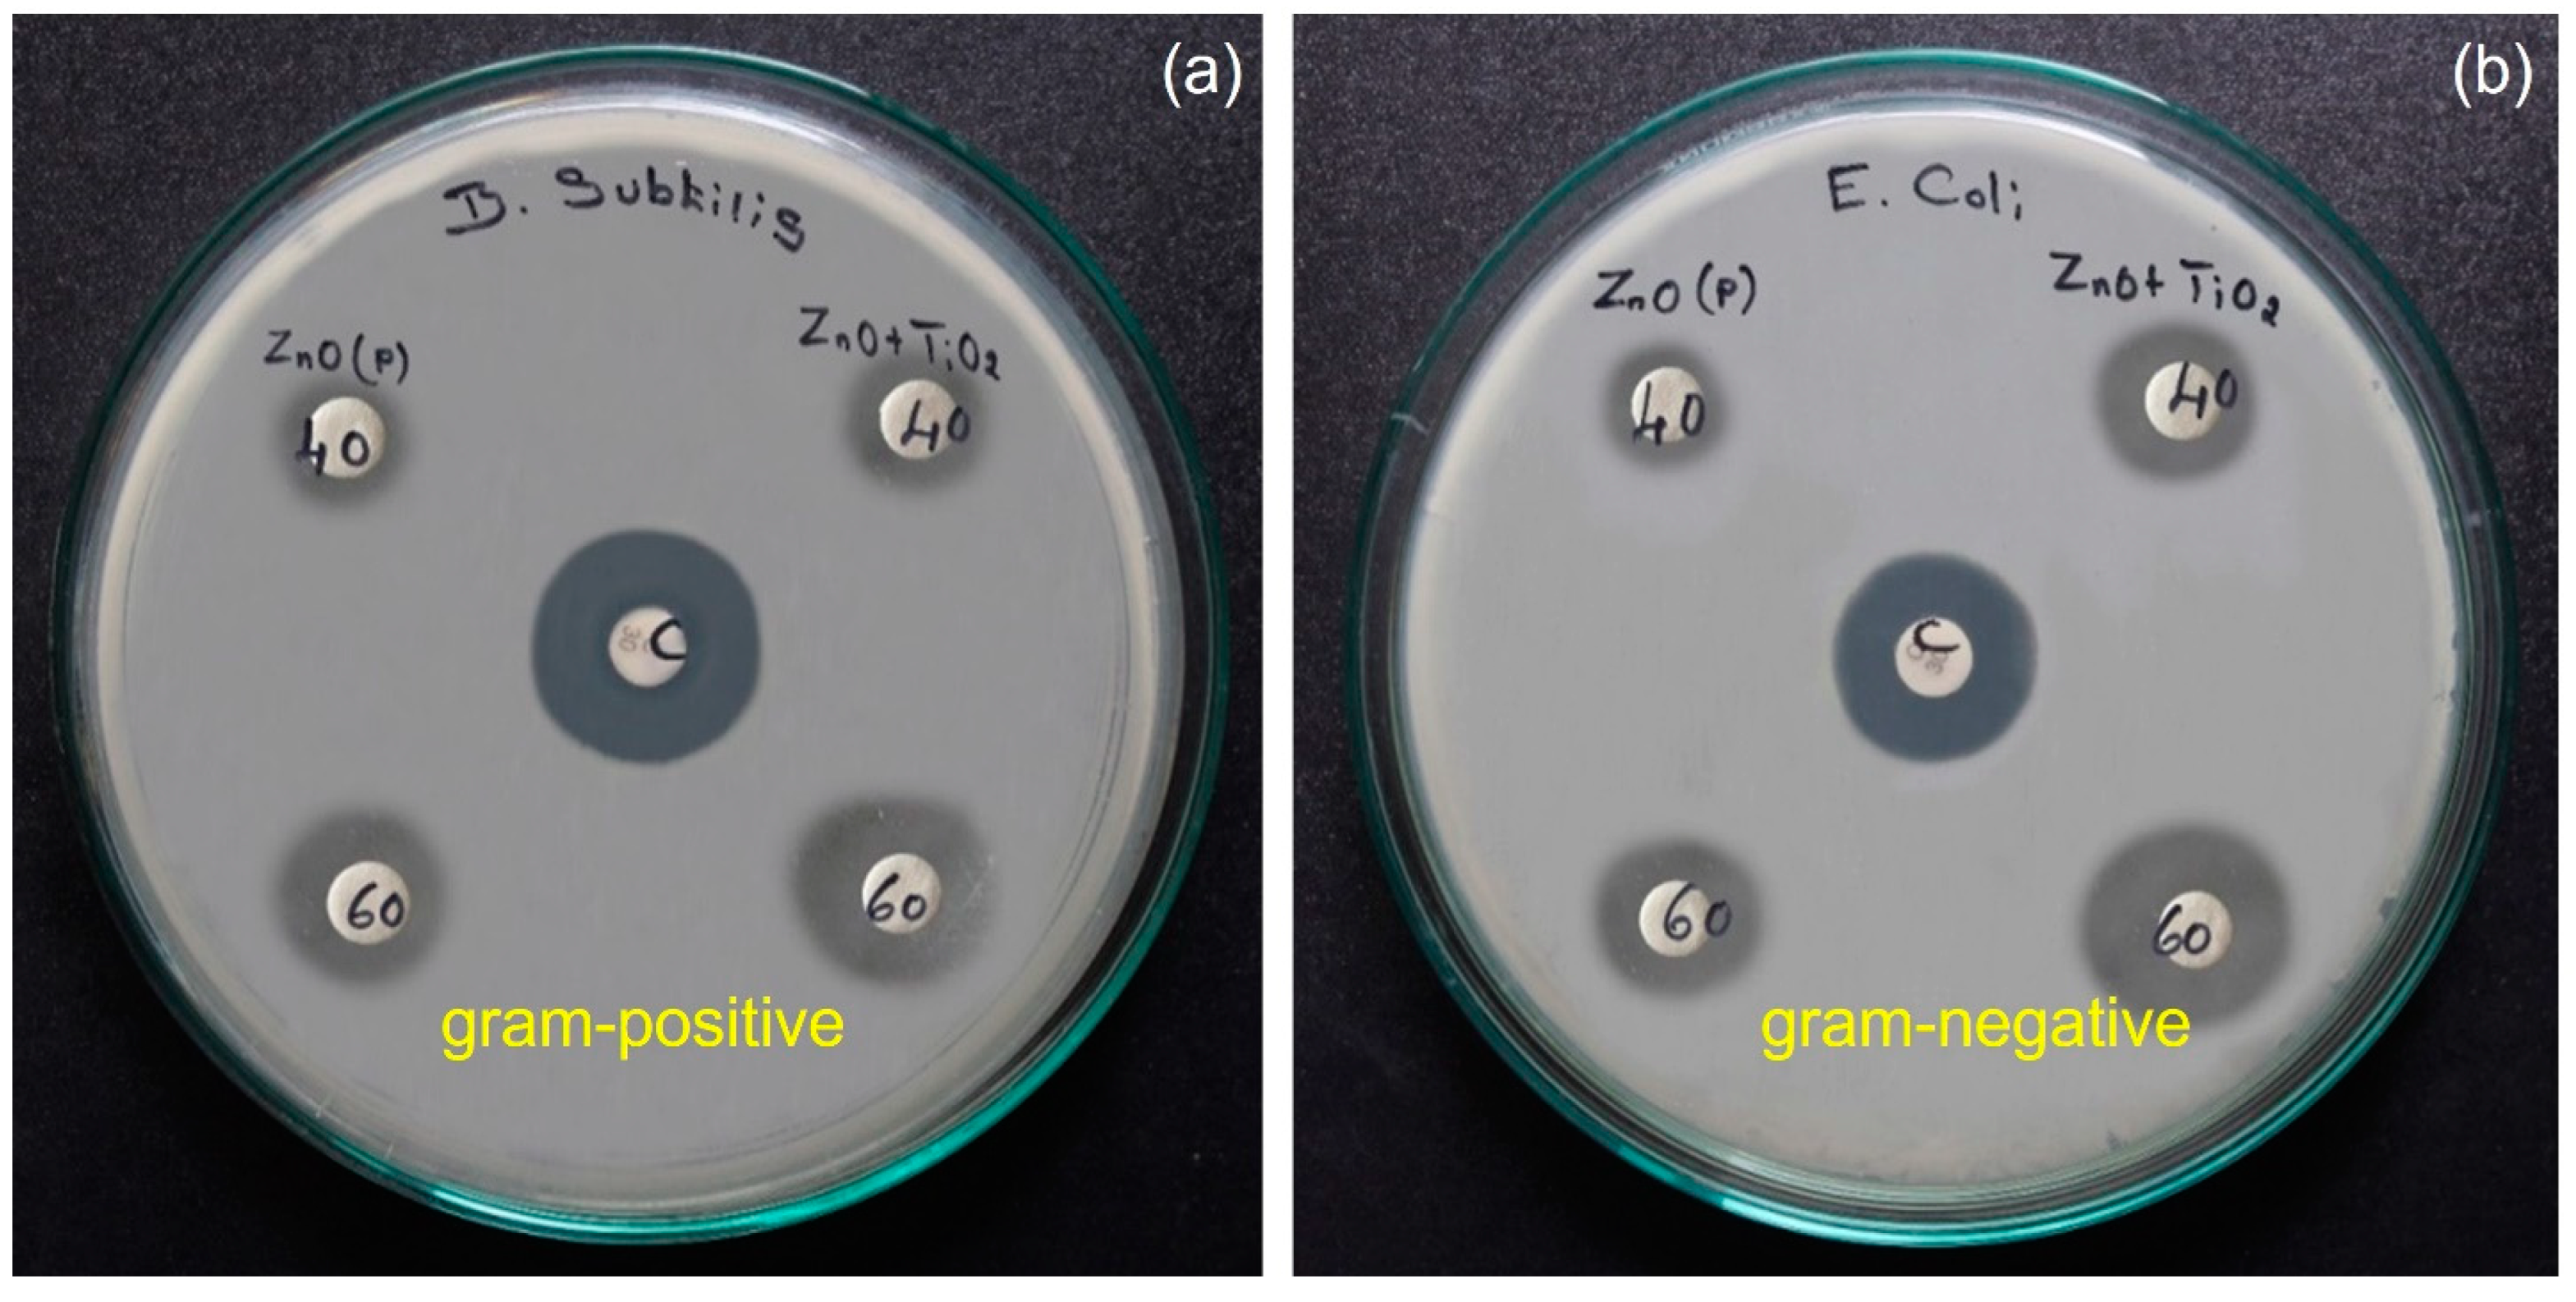
Catalysts 13 00215 g013

Abstract
As a result of the sol-gel method, we were able to produce pure ZnO and ZnO-doped TiO2 nanocomposites. The hexagonal wurtzite phase in ZnO products was discovered by powder X-ray diffraction (XRD). ZnO products are typically hexagonal wurtzite crystallites, formed according to the Debye Scherrer formula. Nanocomposites with significant morphological changes were created using the sol-gel process, including those that resembled rocks. To determine the composition of Zn, O, and Ti atoms in the samples, a multidimensional X-ray analysis was performed. There is an energy gap between 3.61 eV, as determined by UV-vis spectroscopy. In this study, pure ZnO and ZnO-doped TiO2 nanocomposites were used to study the degradation of methylene blue (MB) under visible light irradiation. Over an irradiation course of 6 h, a ZnO-doped TiO2 composite (84%) were studied. As determined by the kinetic analysis, nanocomposites made from pure ZnO and ZnO-doped TiO2 followed pseudo-first-order kinetics. In the presence of ZnO-doped TiO2 nanocomposites, antibacterial activity was significantly improved. This was shown to be effective against Gram-positive and Gram-negative bacteria (Escherichia coli and B. sublittus). There is evidence that the metal oxide nanocomposites that are produced can be used as an appropriate antimicrobial and disinfection alternative, particularly in biomedical settings, as reported in more detail.
1. Introduction
It has been well documented that nanomaterials have superior mechanical, electrical, magnetic, thermal, catalytic, and antimicrobial properties to their bulk counterparts [1,2]. In addition to nanomedicine, nanoelectronics, biomaterials, energy generation, and consumer goods, nanotechnology also has the potential to create a wide range of innovative materials and devices [3,4,5]. One interesting application of ZnO is its hexagonal wurtzite structure, characterized by a two-layer hexagonal close packed (hcp) metal-oxide structure [6,7]. An oxide of a basic metal is known as an oxide of a basic metal [8,9]. Several million kg of zinc alloys are produced annually, mostly as a step in the production process. [10,11]. There is nothing complicated about the structure of ZnO rock salt, as it is the structure of many other binary metal oxides. The Zn:O ratio in ZnO is frequently not stoichiometric, which means that it is not always 1:1. Non-stoichiometric zinc oxide changes colour, whereas stoichiometrically accurate zinc oxide is white. The development of nanoscale materials, which vary in size and morphology, has attracted the attention of diverse industries and technologies [12,13].
A variety of technologies have been developed and employed to produce crystalline oxide powders of nanoscale dimensions. How to synthesize these materials using less energy has been described in several ways, but there are still challenges, including manufacturing capacity limitations and use in production lines [14,15]. In many cases, their main goal is to reduce the cost of chemical synthesis and develop useful materials for technology applications [16,17]. Using sodium hydroxide as the starting component, this study proposes a straightforward and low-cost sol-gel procedure for the synthesis of ZnO nanoparticles. In terms of their electro-optical performance, ZnO nanoparticles are chemically stable and have a large bandgap (3.37 eV). Nanocrystalline ZnO, with a large surface area, is synthesized using a simple chemical approach. Optimizing the parameters, ~pH, and irradiation period of ZnO nanoparticles allowed for them to destroy methylene blue (MB) dyes [18,19,20].
Ion exchange can be achieved for a variety of ions using titanium oxide, which exhibits desirable catalytic and adsorptive properties [21,22]. It is evident that TiO2 (Brookite structure) acts as a bacterial wall, since it has a bandgap of 3.68 eV in the visible light region [23,24]. Brookite, therefore, is photoreactive and photoactive [25,26]. Our study evaluates the structure, microstructure, photocatalytic characteristics, and antimicrobial activity of TiO2-substituted ZnO nanocomposites in light of the above. To our knowledge, there is no report discussing the properties of ZnO-doped TiO2 nanocomposites [27,28,29,30]. With its ZnO-doped bandgap, the TiO2 metal oxide is suitable for photocatalytic applications as well as antimicrobial ones. Our research used the sol-gel approach to synthesize pure ZnO and ZnO-doped TiO2 nanocomposites. To evaluate the nanocomposites generated by this method, researchers used powder X-ray diffraction (PXRD), scanning electron microscopy (SEM), energy-dispersive spectroscopy (EDS), fourier transform infrared spectroscopy (FTIR), ultra-violet visible spectroscopy (UV-vis), Raman spectroscopy and photocatalytic spectroscopy, and Brunauer–Emmett–Teller (BET) and antimicrobial approaches.
2. Results and Discussion
2.1. X-ray Diffraction Analysis
An XRD pattern of nanoparticle powder is shown in Figure 1 to determine their crystallite size and crystalline phase. A significant broadening of the diffraction peaks was observed for the dispersion patterns of films analyzed by X-ray diffraction and ultra-dispersed titanium oxide powders. X-ray diffraction found that the produced materials were cubic symmetry ZnO with identical diffraction peaks to those found in JCPDS File No. 36-1451 [31,32]. Some diffraction peaks correlated well with the ZnO crystal planes (002), (101), (110), (103), and (201), respectively. Using the lattice constants, a = b = 0.324 nm and c = 0.521 nm of (JCPDS File No. 36-1451), we accurately indexed the hexagonal wurtzite phase of ZnO as the peaks in all patterns [33,34]. All crystalline peaks were properly indexed by comparing the TiO2 diffractogram patterns with the JCPDS data files. According to Figure 1, the major peaks at 25.5°, 31.0°, 40.0°, 58.2°, 78°, and 91.4° occurred at the atomic plans (101), (110), (111), (211), (002), and (301), corresponding to those of the tetragonal anatase and rutile TiO2 (JCPDS File No. 21-1272). TiO2 nanocomposites were estimated by Debye–Scherer to have an average crystallite size of 15.93 nm. Figure 1 shows the seven peaks that corresponded to standard hexagonal wurtzite ZnO nanocomposites of 19 nm in diameter (100), (002), (101), (102), (110), (103), and (201). Furthermore, the exhibited composite crystalline phases of both ZnO and TiO2 confirm that both phases were present within the heterostructure [35,36,37,38,39]. Using the Debye–Scherrer formula, we calculated the grain crystallite size. There are several dimensions to the equation: ‘D’ relates to the crystallite size in nanometres D = 0.94λ/cosθ; 0.94 represents the dimensionless constant k; FWHM is the full width at half maximum (FWHM); diffraction angle θ is the diffraction angle; X-ray wavelength is 0.1541 nm. We used Scherrer’s formula to estimate the average particle size of the sample based on the full width at half-maximum (FWHM) of the diffraction peak associated with the plane (101). In order to calculate this, we took the full width at half-maximum (FWHM) of the peak located at 36.33° rotation, corresponding to plane (101).
Figure 1.
X-ray diffraction pattern of pure ZnO and ZnO-doped TiO2 nanocomposites.
2.2. Structural and Elemental Analysis
A series of SEM images of pure ZnO and ZnO doped TiO2 nanocomposites is shown in Figure 2a–i. Due to particle aggregation, many particles displayed irregular spherical morphology upon SEM imaging. Additionally, the pictures clearly show that the grain size was typically less than 10 nm. The large surface area of the catalyst enhances its photocatalytic activity. The size of ZnO-doped TiO2 nanocomposites does not differ from that of ZnO without TiO2, but the size of the holes decreases with the addition of TiO2. This SEM image shows numerous nano-sized growth sites on the surface of ZnO nanoparticles. In Figure 3a,b, ZnO is shown as pure nanoparticles and ZnO-doped TiO2 nanocomposites, supposedly Zn and O, are the components of the synthetic nanoparticles made up of Zn and O. In addition, this study confirms that ZnO nanoparticles contain Ti-ion. Based on the results, the nanocomposites are composed of Zn, Ti, and O, confirming that Ti was substituted for Zn in ZnO. Ti is present in the doped samples at a concentration of 27.85%. ZnO nanocomposites have a chemical composition of 37.89% Zn and 34.26% O. Zn-doped TiO2 nanocomposites, however, have lower zinc contents and slightly higher oxygen contents [40].
Figure 2.
(a–i) SEM of pure ZnO and ZnO doped TiO2 nanocomposites.
Figure 3.
(a,b) Pure ZnO and ZnO-doped TiO2 nanocomposites analyzed by EDAX analysis.
2.3. UV-Vis Measurements
As can be seen in Figure 4, pure ZnO and ZnO-doped TiO2 nanocomposites were analyzed using UV-vis spectroscopy. At wavelengths of nearly 213 and 282 nm, the greatest absorption peak is observed in the as-prepared sample [41,42,43]. Moreover, a commercial bulk ZnO nanoparticles shows no discernible absorption band in the UV-vis spectrum. The absorption spectra of ZnO-doped TiO2 nanocomposites were used to estimate their optical bandgaps. E = hc/λ (eV); where, ‘h’ is Planck’s constant (6.626 × 10−34 Js), ‘c’ is the velocity of light (3 × 108 m/s), ‘λ’ is an absorbance waveband with a sharp peak, corresponding to a wavelength. There is a solid shoulders’ peak of around 343 nm in the ZnO sample, which is a pretty blue colour, and is shifted away from the absorption edge derived from UV absorption [44]. As it has a higher value than ZnO-doped TiO2 (Eg = 3.61 eV), the produced ZnO is widely believed to be nanoscale [45,46].
Figure 4.
UV-visible spectrum of synthesized pure ZnO and ZnO-doped TiO2 nanocomposites.
2.4. FTIR Analysis
In Figure 5, the main functional group in the catalyst was determined using FTIR at room temperature. This is due to the stretching vibrations of the zinc oxygen bond, and the FTIR spectra peaks at 483 cm−1, 597 cm−1, and 881 cm−1. An elongated peak indicates that the ZnO catalyst is crystalline [15,47]. The symmetrical and asymmetric stretch of CO2 molecule vibration modes occurs due to the absorption of CO2 molecules from the air. This may be due to the stretching and bending vibrations of the -OH group that was absorbed on the catalyst surface during FTIR analysis, explaining the broad peaks at 3377 cm−1, 3491 cm−1, and 3569 cm−1 [48,49,50].
Figure 5.
Doped TiO2 nanocomposites synthesized with pure ZnO as the doped component are shown in the FTIR spectrum.
2.5. Raman Spectroscopy Analysis
Raman scattering can be used to study anions and cations, lattice distortions, and the distribution of lattice defects. This can be seen in Figure 6. The Raman spectrum of ZnO-doped TiO2 nanocomposites at ambient temperature includes many bands between 500 cm−1 and 4000 cm−1. The broad and strong peaks shift to a lower frequency when the Zn ions’ mass is increased, because Zn ions have a larger mass than Ti ions. In an interesting coincidence, similarly to how electronic frequency is affected by cell volume, the Zn-O stretching mode is commonly attributed to the Raman spectrum’s high, broad peak at 116 cm−1. The Ti substitution Zn is produced at the Zn site. ZnO reduces this lattice parameter and cell volume, as was shown previously in X-ray diffraction patterns. Increasing the lattice cell characteristics suggests that a ZnO-doped TiO2 nanoparticle is present in the Raman modes, as indicated by the blue shift. As a result of the lattice contraction, the average bond length of the cell is shortened. According to the Raman vibrational spectrum, the peak at 1080 cm−1 indicates a shift from red to blue, suggesting a shift in the Raman modes. In addition to the different synthesis temperatures and strained lattices, structural defects could also contribute to the change in peak location [51,52,53].
Figure 6.
Raman spectrum of synthesized pure ZnO and ZnO doped TiO2 nanocomposites.
2.6. Photocatalytic Analysis
UV/visible spectroscopy was performed using pure ZnO and ZnO-doped TiO2 nanocomposites as a photocatalyst on aqueous solutions of 20 ppm MB dye [29,54]. When the illumination period was extended, there was a greater degradation of organic pollutants into non-toxic substituents, as shown by the decrease in the absorption peak. When compared to pure zinc oxide, ZnO-doped TiO2 nanocomposites show the greatest degradation rate. As shown in Figure 7, an MB dye solution with ZnO-doped TiO2 has a time-dependent UV-vis absorption spectrum. There is, however, a significant difference between the two samples in terms of the rate at which the maximum absorbance values decrease. In both cases, the relative absorption peak intensity dramatically decreased with an increase in visible light illumination [55,56]. Therefore, we conclude that both catalyst powders are photoactive.
Figure 7.
As a result of ZnO-doped TiO2 nanocomposites, the ultraviolet-visible absorption spectrum of MB is observed.
Afterward, the efficiacy of the samples was tested to determine whether they were degrading, as shown in Figure 8. To determine the degradation profile of MB dye over time, ZnO-doped TiO2 nanocomposites were irradiated with visible light. In the presence of ZnO-doped TiO2 nanocomposites, the samples degraded with 84% efficiency [57,58,59,60]. The high surface area of ZnO-doped TiO2 nanocomposites allows for them to interact with many molecules. A photon with an energy level above the bandgap excites the photocatalyst and elevates electrons from the valence band (VB) to the conduction band (CB). These electrons produce superoxide radicals when they react with the oxygen dissolved in the solution, and OH- is converted into •OH radicals as a result of these reactions. The mechanism of this can be described by the following equations:
ZnO doped TiO2 NPs + hυ ⟶ ZnO doped TiO2 NPs + (e−/h+)
e− + O2⟶ ·O−
h+ + OH− ⟶ :OH
h+ VB + OH/H2O → HO* + H+
HO* + MB dye → degraded product
Figure 8.
Photocatalytic degradation efficiency bar diagram of ZnO-doped TiO2 nanocomposites.
The electron acceptor, energy absorber, and radical generator of hydrogen peroxide is essential for photocatalytic reactions. The recombination rate of electrons and holes will decrease as a result. It is expected that dye molecules will be broken down by anions of superoxide radicals and the hydroxyl radicals that are produced [4,10,17,20].
To provide precise kinetic data, first-order kinetics were applied to the photodecomposition of MB dye [21,22,23]. In the equation C/Co = −kt, K represents the rate constant and T represents the reaction time, where Co represents the initial dye concentration and C represents the final dye concentration. As shown in Figure 9a,b, (C/Co) and ln(Co/Ct) plots relate to time. According to the total percentage of photodegradation and photodegradation kinetics, ZnO-doped TiO2 has a much higher photocatalytic activity than ZnO. In Figure 10, visible light is irradiated and produces a photocatalytic reaction, while pure ZnO and ZnO-doped TiO2 have different properties. This is because ZnO absorbs visible light, allowing for it to capture and produce electrons from the photoinduced electrons [27,40]. Consequently, the results show that pure ZnO nanoparticles and ZnO-doped TiO2 nanocomposites both exhibit good photocatalytic activity for MB dye under visible-light illumination.
Figure 9.
(a,b) Infrared irradiation time-dependence of (C/Co) and light-exposure time-dependence of (C/Ct) for ZnO-doped TiO2 nanocomposites.
Figure 10.
ZnO-doped TiO2 nanocomposites and their proposed photocatalytic mechanism.
2.7. BET Analysis
A nitrogen adsorption–desorption analysis was used to determine the specific surface area and porous structure of ZnO-doped TiO2 nanocomposites, which contribute to their photocatalytic activity. Several samples have mesoporous characteristics and type IV isotherms [24,51,56]. An enhanced surface area and pore size distribution was observed for nanomaterials doped with ZnO/TiO2 (24.12 cm2/g and 1.89 nm) when compared with bare ZnO (14.67 cm2/g and 1.89 nm). When dyes degrade, electrons travel more efficiently through the pores, due to their larger size and volume. Increasing the surface-active material sites increases their catalytic activity, which is enhanced by the large surface area. Figure 11 shows the N2 adsorption–desorption isotherms used to determine the BET surface area of harvested samples. The distribution of pore sizes is also shown in Figure 12, and Dubinin and Astakov’s (DA) method was used to calculate the pore radius of the synthesized materials.
Figure 11.
The surface area of pure ZnO and ZnO-doped TiO2 nanocomposites and their relative pressures vs. the adsorbed volumes according to BET coefficients.
Figure 12.
Pore size distribution for pure ZnO and ZnO-doped TiO2 nanocomposites.
2.8. Antibacterial Activity
2.8.1. An Overview of Inoculum Preparation
Agar slopes containing nutrients were grown at 4 °C for stock cultures. Test tubes containing Muller-Hinton broth (MHB) and bacteriophages were filled with loopfuls of cells from stock cultures and incubated without agitation for 24 h at 37 °C or 25 °C. It was possible to achieve 2.0 × 106 colony-forming units per millilitre by diluting the cultures in fresh Muller–Hinton broth.
2.8.2. Antimicrobial Susceptibility Test
The disc-diffusion test was developed by Bauer et al., in 1966, as a means of detecting antimicrobial activity. Himedia (Mumbai) provided Muller-Hinton Agar (MHA) for the screening of in vitro antimicrobial activity [25,61]. A sterile petri-plate was prepared by pouring molten media into 15 mL of sterile petri-plates. The coating of the 0.1% inoculum solution was followed by the uniform swabbing of plates with the 0.1% inoculum solution, followed by five minutes of drying. Extracts with a concentration of 40 mg were loaded onto sterile discs. A loaded disc was placed on the medium surface and allowed to diffuse for 5 min before incubation at 37 °C for 24 h. As shown in Figure 13a,b, inhibition zones were measured in millimetres around the disc after incubation. For bacteria to be killed by pure zinc-oxide nanocomposites, a nanocomposite concentration of as low as 40 mg is required during incubation [26,62].
Figure 13.
(a,b). Bacillus subtilis and Escherichia coli were shown to be susceptible to antibacterial action by pure ZnO and ZnO-doped TiO2 nanocomposites.
2.9. Screening of Antifungal Activity
2.9.1. Tested Fungi
One fungus strain was used during the course of the investigation (C. albicans). All fungal cultures were taken from the Microbial Type Culture Collection (MTCC) at the Institute of Microbial Technology in Chandigarh, India. The screening procedure began with the preparation of young fungal broth cultures. To assess the antifungal properties of Sabouraud’s dextrose agar/broth, Hi Media Pvt. conducted antifungal tests. After inoculating each strain in Sabouraud’s dextrose broth for six hours, each suspension contained approximately 105 CFU/mL.
2.9.2. Determination of Antifungal Activity
Diffusion was obtained using agar wells, as described in Perez, 1993. This is most commonly used to cultivate fungi on Sabouraud’s dextrose agar (SDA). The innoculation of the culture medium with separate suspensions of fungal strains was carried out using Sabouraud’s dextrose broth. To prepare the wells, an 8 mm diameter hole was punched into each of the agar and solvent blanks, and methanol, ethyl acetate and hexane were poured into the holes. A standard antibiotic (Fucanazole, concentration 1 mg/mL) was used to incubate fungal plates at 37 °C for 72 h. As shown in Figure 14, the diameters of the inhibition zones were measured. The antifungal activity of zinc oxide doped with TiO2 NPs can be seen in the inhibition zone of bacteria growth [63,64,65]. Antimicrobial agents that contain metal nanocomposites, such as Zn, Ti, and Ag, may be created by oxide nanocomposites containing these metals.
Figure 14.
Antifungal activity of pure ZnO and ZnO-doped TiO2 NPs against Candida albicans stains.
3. Experimental
3.1. Preparation of Pure Zinc Oxide and ZnO Doped TiO2 Nanocomposites
We used all chemical reagents (analytical grade) without further purification (E-Merck 99.99%). With the aid of the sol-gel method, pure ZnO was produced by combining Zn(NO3)2 and NaOH. To prepare ZnO, an aqueous zinc nitrate solution containing 3 M was stirred continuously for two hours with a magnetic stirrer until it was completely dissolved, accompanied by a solution of 3 M sodium hydroxide (NaOH). As the zinc nitrate dissolved, the aqueous solution was added drop by drop under high-speed stirring. A three-hour running time was allowed after sodium hydroxide was completely added. The beaker was covered carefully and this condition was maintained overnight. A careful observation was made the following day to separate the supernatant solution. After centrifuging the remaining solution, the precipitate was removed. In addition, the precipitate was repeatedly washed with distilled water to remove contaminants. The dried Zn(OH)2 particles were then annealed at 70 °C for two hours to convert them into ZnO nanocomposites using a muffle furnace. In the same way, ZnO-doped TiO2 nanocomposites was prepared via the same method by adding TiO2 to the solution for doping. Dopant stoichiometry can be controlled by correctly dissolving titanium oxide. As prepared, the solutions had a concentration of 0.4 M. Stirring the mixture at 80 °C for 4 h produced a homogeneous and clear solution. Using a slow cooling method, air-cooled solutions were cooled to room temperature and then aged for 24 h at that temperature. Following annealing at 600 °C in an air furnace for two hours, the samples were kept at room temperature.
3.2. Characterization Studies
A RigaKu D/max-RB diffractometer at 40 kV and 30 mA was used to perform powder X-ray diffraction (XRD) experiments. The XRD spectra were recorded for angles (2θ) ranging from 10° to 90°. A JEOL JSM-5300 microscope with acceleration voltage 15 kV was used to examine the surface morphology of the synthesized samples. Using the IH-300X, selected area electron diffraction (SAED) was used to determine the elements’ compositions. In this experiment, spectra were recorded with a spectrometer (Brukker IFS-66V). A UV-vis-NIR spectrophotometer (JASCO V-550, Tokyo, Japan) was used to study the optical properties of ZNO-doped TiO2 nanocomposites. A Brukker IFS (66 V) spectrometer was used to study the ZnO-doped TiO2 nanocomposites’ functional groups, using fourier transform infrared spectroscopy (FTIR). A backscattering Ocean optics ID Raman spectrometer (Dunedin, FL, USA), with a wavelength of 785 nm and power of 70 mW, was used for Raman spectroscopy studies.
3.3. Photocatalytic Performance Measurement
A ZnO-doped TiO2 nanocomposite was used to photocatalyze methylene blue (MB) degradation under UV light (400 nm) and visible light in aqueous solution. The MB solution was mixed with 40 mg of catalyst at a fixed concentration in 100 mL of MB solution under UV light. To achieve adsorption–desorption equilibrium, the catalyst/MB solution was kept in the dark for 2 h. To accelerate dye degradation, H2O2 was added to increase the generation of -OH radicals during photodegradation. Under stirred conditions, UV light was exposed through 100 mL of catalyst-loaded MB aqueous solution with simultaneous exposure to UV light. Air was purged to ensure that the catalyst was well dispersed in the solution. MB mixture solution was irradiated with UV for 30 min at a time. A UV-visible spectrophotometer was used to measure changes in the absorption band maximum at given time intervals after the photo-reacted solution of the centrifuged sample was withdrawn from the UV-illuminated solution (2 mL every time).
4. Conclusions
To remove dye-induced, unsafe water pollution, pure ZnO and ZnO-doped TiO2 nanocomposites were synthesized using the sol-gel approach. A variety of investigation methods were employed to analyze the prepared ZnO-doped TiO2 nanocomposites, including XRD, SEM, EDX, FTIR and Raman spectra. In an XRD analysis of ZnO-doped TiO2 nanocomposites with a crystalline size of 8.92 nm, they were found to be spherical in shape. It was possible to effectively remove colours from aqueous solutions using ZnO/TiO2 nanocomposites. When ~pH was increased in MB solutions, the photocatalytic degradation rate increased. It was found that when ZnO-doped TiO2 nanocomposites were photocatalyzed, they were able to degrade MB dye by 84%. The inhibition of MB dye evaporation by pure ZnO and doped TiO2 nanocomposites indicates that the synthesized candidate is suitable for degradation devices. According to BET surface area measurements, pure ZnO and doped TiO2 nanocomposites have a specific surface area of 69 m2/g, while ZnO-doped TiO2 nanocomposites have a specific surface area of 46 m2/g. Antibiotic-resistant pure ZnO NPs doped with TiO2 were demonstrated to be effective against Gram-negative and Gram-positive bacteria. According to specific antimicrobial studies, microorganisms exposed to antimicrobial activity of ZnO with TiO2 nanocomposites showed cell inactivation at the levels of signalling and regulatory networks.
Author Contributions
Conceptualization, A.K.R. and U.R.; Methodology, A.G., A.K.R., I.C. and U.R.; Software, A.G., A.K.R., I.C. and U.R.; Validation, A.K.R., C.M., I.C. and K.K.; Formal analysis, A.G., A.K.R., I.C., U.R. and K.K.; Investigation, A.G., A.K.R., C.M., I.C. and U.R.; Resources, A.G., A.K.R. and C.M.; Data curation, A.G., A.K.R., C.M. and I.C.; Writing—original draft, A.G., A.K.R. and U.R.; Writing—review & editing, A.K.R., C.M. and I.C.; Visualization, I.C. and K.K.; Supervision, A.K.R., I.C. and U.R.; Project administration, A.K.R. and C.M. All authors have read and agreed to the published version of the manuscript.
Funding
This research received no external funding.
Data Availability Statement
The datasets generated during and/or analyzed during the current study are available from the corresponding author on reasonable request.
Conflicts of Interest
The authors declare that they have no competing interests.
References
- Jayakumar, G.; Irudayaraj, A.; Raj, A.; Sundaram, S.; Kaviyarasu, K. Electrical and magnetic properties of Ni doped CeO2 nanostructured for optoelectronic applications. J. Phys. Chem. Solids 2022, 160, 110369. [Google Scholar] [CrossRef]
- Alhokbany, N.; Ahamad, T.; Alshehri, S.M. Fabrication of highly porous ZnO/Ag2O nanocomposites embedded in N-doped graphitic carbon for photocatalytic degradation of tetracycline. J. Environ. Chem. Eng. 2022, 10, 107681. [Google Scholar] [CrossRef]
- Sharath, R.; Fang, F.; Futter, J.; Trompetter, W.; Singh, G.; Vinu, A.; Kennedy, J. Nitrogen defect engineering in porous g-C3N4 via one-step thermal approach. Emergent Mater. 2022, 421, 1–9. [Google Scholar] [CrossRef]
- Panimalar, S.; Logambal, S.; Thambidurai, R.; Inmozhi, C.; Uthrakumar, R.; Muthukumaran, A.; Rasheed, R.A.; Gatasheh, M.; Raja, A.; Kennedy, J.; et al. Effect of Ag doped MnO2 nanostructures suitable for wastewater treatment and other environmental pollutant applications. Environ. Res. 2022, 205, 112560. [Google Scholar] [CrossRef]
- Jamil, M.; Wei, S.; Taylor, M.P.; Chen, J.J.; Kennedy, J.V. Hybrid anode materials for rechargeable batteries-A review of Sn/TiO based nanocomposites. Energy Rep. 2021, 7, 2836–2848. [Google Scholar] [CrossRef]
- Fang, F.; Futter, J.; Markwitz, A.; Kennedy, J. UV and humidity sensing properties of ZnO nanorods prepared by the arc discharge method. Nanotechnology 2009, 20, 245502. [Google Scholar] [CrossRef]
- Kennedy, J.; Murmu, P.; Manikandan, E.; Lee, S. Investigation of structural and photoluminescence properties of gas and metal ions doped zinc oxide single crystals. J. Alloy. Compd. 2014, 616, 614–617. [Google Scholar] [CrossRef]
- Singh, P.; Nanda, A. Enhanced sun protection of nano-sized metal oxide particles over conventional metal oxide particles: An in vitro comparative study. Int. J. Cosmet. Sci. 2014, 36, 273–283. [Google Scholar] [CrossRef]
- Rekha, K.; Nirmala, M.; Nair, M.G.; Anukaliani, A. Structural, optical, photocatalytic and antibacterial activity of zinc oxide and manganese doped zinc oxide nanocomposites. Phys. B Condens. Matter. 2010, 405, 3180–3185. [Google Scholar] [CrossRef]
- Nagasundari, S.M.; Muthu, K.; Kaviyarasu, K.; AlFarraj, D.A.; Alkufeidy, R.M. Current trends of Silver doped Zinc oxide nanowires photocatalytic degradation for energy and environmental application. Surf. Interfaces 2021, 23, 100931. [Google Scholar] [CrossRef]
- Vinayagam, R.; Sharma, G.; Murugesan, G.; Pai, S.; Gupta, D.; Narasimhan, M.; Kaviyarasu, K.; Varadavenkatesan, T.; Selvaraj, R. Rapid photocatalytic degradation of 2,4-dichlorophenoxy acetic acid by ZnO nanocomposites synthesized using the leaf extract of Muntingia calabura. J. Mol. Struct. 2022, 1263, 133127. [Google Scholar] [CrossRef]
- Justine, M.; Prabu, H.J.; Johnson, I.; Raj, D.M.A.; Sundaram, S.J.; Kaviyarasu, K. Synthesis and characterizations studies of ZnO and ZnO-SiO2 nanocomposite for biodiesel applications. Mater. Today Proc. 2021, 36, 440–446. [Google Scholar] [CrossRef]
- Anand, G.; Nithiyavathi, R.; Ramesh, R.; Sundaram, S.; Kaviyarasu, K. Structural and optical properties of nickel oxide nanocomposites: Investigation of antimicrobial applications. Surf. Interfaces 2020, 18, 100460. [Google Scholar] [CrossRef]
- Kaviyarasu, K.; Magdalane, C.M.; Kanimozhi, K.; Kennedy, J.; Siddhardh, B.; Reddy, E.S.; Rotte, N.K.; Sharma, C.S.; Thema, F.; Letsholathebe, D.; et al. Elucidation of photocatalysis, photoluminescence and antibacterial studies of ZnO thin films by spin coating method. J. Photochem. Photobiol. B Biol. 2017, 173, 466–475. [Google Scholar] [CrossRef] [PubMed]
- Chandrasekar, M.; Panimalar, S.; Uthrakumar, R.; Kumar, M.; Saravanan, M.R.; Madheswaran, G.G.P.; Inmozhi, C.; Kaviyarasu, K. Preparation and characterization studies of pure and Li+ doped ZnO nanocomposites for optoelectronic applications. Mater. Today Proc. 2021, 36, 228–231. [Google Scholar] [CrossRef]
- Reinert, A.; Payne, C.; Wang, L.; Ciston, J.; Zhu, Y.; Khalifah, P.G. Synthesis and characterization of visible light absorbing (GaN)1−x(ZnO)x semiconductor nanorods. Inorg. Chem. 2013, 52, 8389–8398. [Google Scholar] [CrossRef]
- Magdalane, C.; Priyadharsini, G.; Kaviyarasu, K.; Jothi, A.; Simiyon, G. Synthesis and characterization of TiO2 doped cobalt ferrite nanocomposites via microwave method: Investigation of photocatalytic performance of congo red degradation dye. Surf. Interfaces 2021, 25, 101296. [Google Scholar] [CrossRef]
- Alhaji, N.; Nathiya, D.; Kaviyarasu, K.; Meshram, M.; Ayeshamariam, A. A comparative study of structural and photocatalytic mechanism of AgGaO2 nanocomposites for equilibrium and kinetics evaluation of adsorption parameters. Surf. Interfaces 2019, 17, 100375. [Google Scholar] [CrossRef]
- Choi, M.; Lim, J.; Baek, M.; Choi, W.; Kim, W.; Yong, K. Investigating the Unrevealed Photocatalytic Activity and Stability of Nanostructured Brookite TiO2 Film as an Environmental Photocatalyst. ACS Appl. Mater. Interfaces 2017, 9, 16252–16260. [Google Scholar] [CrossRef]
- Perumal, V.; Uthrakumar, R.; Chinnathambi, M.; Inmozhi, C.; Robert, R.; Rajasaravanan, M.; Raja, A.; Kaviyarasu, K. Electron-hole recombination effect of SnO2-CuO nanocomposite for improving methylene blue photocatalytic activity in wastewater treatment under visible light. J. King Saud Univ. Sci. 2023, 35, 102388. [Google Scholar] [CrossRef]
- Zhuang, B.; Shi, H.; Zhang, H.; Zhang, Z. Sodium doping in brookite TiO2 enhances its photocatalytic activity. Beilstein J. Nanotechnol. 2022, 13, 599–609. [Google Scholar] [CrossRef] [PubMed]
- Luttrell, T.; Halpegamage, S.; Tao, J. Why is anatase a better photocatalyst than rutile?-Model studies on epitaxial TiO2 films. Sci. Rep. 2014, 4, 4043. [Google Scholar] [CrossRef] [PubMed]
- Liu, L.; Zhao, H.; Andino, J.; Li, Y. Photocatalytic CO2 reduction with H2O on TiO2 nanocrystals: Comparison of anatase, rutile and brookite polymorphs and exploration of surface chemistry. ACS Catal. 2012, 2, 1817–1828. [Google Scholar] [CrossRef]
- Ye, X.; Sha, J.; Jiao, Z.; Zhang, L. Thermoanalytical characteristic of nanocrystalline brookite-based titanium dioxide. Nanostructured Mater. 1997, 8, 919–927. [Google Scholar] [CrossRef]
- Kandiel, T.; Robben, L.; Alkaima, A. Brookite versus anatase TiO2 photocatalysts: Phase transformations and photocatalytic activities. Photochem. Photobiol. Sci. 2013, 12, 602–609. [Google Scholar] [CrossRef]
- Zhang, J.; Zhou, P.; Liu, J.; Yu, J. New understanding of the difference of photocatalytic activity among anatase, rutile and brookite TiO2. Phys. Chem. Chem. Phys. 2014, 16, 20382–20386. [Google Scholar] [CrossRef]
- Kasinathan, K.; Kennedy, J.; Elayaperumal, M.; Henini, M.; Malik, M. Photodegradation of organic pollutants RhB dye using UV simulated sunlight on ceria based TiO2 nanomaterials for antibacterial applications. Sci. Rep. 2016, 6, 38064. [Google Scholar] [CrossRef]
- Geetha, N.; Sivaranjani, S.; Ayeshamariam, A.; Bharathy, M.S.; Nivetha, S.; Kaviyarasu, K.; Jayachandran, M. High performance photo-catalyst based on nanosized ZnO-TiO2 nanoplatelets for removal of RhB under visible light irradiation. J. Adv. Microsc. Res. 2018, 13, 12–19. [Google Scholar] [CrossRef]
- Kaviyarasu, K.; Devarajan, P.A. A convenient route to synthesize hexagonal pillar shaped ZnO nanoneedles via CTAB surfactant. Adv. Mater. Lett. 2013, 4, 582–585. [Google Scholar] [CrossRef]
- Dhayagude, A.; Nikam, S.; Kapoor, S.; Joshi, S. Effect of electrolytic media on the photophysical properties and photocatalytic activity of zinc oxide nanocomposites synthesized by simple electrochemical method. J. Mol. Liq. 2017, 232, 290–303. [Google Scholar] [CrossRef]
- Stan, M.; Popa, A.; Toloman, D.; Silipas, T.; Vodnar, D. Antibacterial and antioxidant activities of ZnO nanocomposites synthesized using extracts of Allium sativum, Rosmarinus ocinalis and Ocimum basilicum. Acta Met. Sin. Engl. Lett. 2016, 29, 228–236. [Google Scholar] [CrossRef]
- Yao, Y.; Cao, Q. First-principles study on infrared absorptions of transition metal-doped ZnO with oxygen vacancy. Acta. Metall. Sin. Engl. Lett. 2013, 26, 467–472. [Google Scholar] [CrossRef]
- Raja, A.; Ashokkumar, S.; Marthandam, R.P.; Jayachandiran, J.; Khatiwada, C.P.; Kaviyarasu, K.; Raman, R.G.; Swaminathan, M. Eco-friendly preparation of zinc oxide nanocomposites using Tabernaemontana divaricata and its photocatalytic and antimicrobial activity. J. Photochem. Photobio. B Biol. 2018, 181, 53–58. [Google Scholar] [CrossRef] [PubMed]
- Archana, K.J.; Preetha, A.C.; Balasubramanian, K. Influence of Urbach energy in enhanced photocatalytic activity of Cu doped ZnO nanocomposites. Opt. Mater. 2022, 127, 112245. [Google Scholar] [CrossRef]
- Othman, A.; Osman, M.; Ibrahim, E.; Ali, M. Sonochemically synthesized ZnO nanosheets and nanorods: Annealing temperature effects on the structure, and optical properties. Ceram. Int. 2017, 43, 527–533. [Google Scholar] [CrossRef]
- Gancheva, M.; Velichkova, M.M.; Atanasova, G.; Kovacheva, D.; Uzunov, I.; Cukeva, R. Design and photocatalytic activity of nanosized zinc oxides. Appl. Surf. Sci. 2016, 368, 258–266. [Google Scholar] [CrossRef]
- Gancheva, M.; Uzunov, I.; Iordanova, R.; Papazova, K. Influence of the preparation method on the structure, optical and photocatalytic properties of nanosized ZnO. Mater. Chem. Phys. 2015, 164, 36–45. [Google Scholar] [CrossRef]
- Vafaee, M.; Ghamsari, M.; Radiman, S. Highly concentrated zinc oxide nanocrystals sol with strong blue emission. J. Lumin. 2011, 131, 155–158. [Google Scholar] [CrossRef]
- Dette, C.; Osorio, M.P.; Kley, C.; Punke, P.; Patrick, C.; Jacobson, P.; Giustino, F.; Jung, S.; Kern, K. TiO2 Anatase with a Bandgap in the Visible Region. Nano Lett. 2014, 14, 6533–6538. [Google Scholar] [CrossRef]
- Vinayagam, R.; Kandati, S.; Murugesan, G.; Goveas, L.C.; Baliga, A.; Pai, S.; Varadavenkatesan, T.; Kaviyarasu, K.; Selvaraj, R. Bioinspiration synthesis of hydroxyapatite nanoparticles using eggshells as a calcium source: Evaluation of Congo red dye adsorption potential. J. Mater. Res. Technol. 2023, 22, 169–180. [Google Scholar] [CrossRef]
- Piras, A.; Olla, C.; Reekmans, G.; Kelchtermans, A.; Sloovere, D.; Elen, K.; Carbonaro, C.; Fusaro, L.; Adriaensens, P.; Hardy, A.; et al. Photocatalytic Performance of Undoped and Al-Doped ZnO Nanocomposites in the Degradation of Rhodamine B under UV-Visible Light: The Role of Defects and Morphology. Int. J. Mol. Sci. 2022, 23, 15459. [Google Scholar] [CrossRef] [PubMed]
- Bazzani, M.; Neroni, A.; Calzolari, A.; Catellani, A. Optoelectronic Properties of Al:ZnO: Critical Dosage for an Optimal Transparent Conductive Oxide. Appl. Phys. Lett. 2011, 98, 121907. [Google Scholar] [CrossRef]
- Abrinaei, F.; Molahasani, N. Effects of Mn Doping on the Structural, Linear, and Nonlinear Optical Properties of ZnO Nanocomposites. J. Opt. Soc. Am. B 2018, 35, 2015. [Google Scholar] [CrossRef]
- Calzolari, A.; Catellani, A. Doping, Co-Doping, and Defect Effects on the Plasmonic Activity of ZnO-Based Transparent Conductive Oxides. Oxide-Based Mater. Devices VIII 2017, 12, 101050G. [Google Scholar]
- Mahdavi, R.; Talesh, S. The effect of ultrasonic irradiation on the structure, morphology and photocatalytic performance of ZnO nanocomposites by sol-gel method. Ultrason. Sonochem. 2017, 39, 504. [Google Scholar] [CrossRef]
- Ghoderao, K.; Jamble, S.; Kale, R. Influence of pH on hydrothermally derived ZnO nanostructures. Optik 2018, 156, 758. [Google Scholar] [CrossRef]
- Nandi, P.; Das, D. Photocatalytic Degradation of Rhodamine-B Dye by Stable ZnO Nanostructures with Different Calcination Temperature Induced Defects. Appl. Surf. Sci. 2019, 465, 546–556. [Google Scholar] [CrossRef]
- Djelloul, A.; Aida, M.; Bougdira, J. Photoluminescence, FTIR and X-ray Diffraction Studies on Undoped and Al-Doped ZnO Thin Films Grown on Polycrystalline α-Alumina Substrates by Ultrasonic Spray Pyrolysis. J. Lumin. 2010, 130, 2113–2117. [Google Scholar] [CrossRef]
- Munawaroh, H.; Wahyuningsih, S.; Ramelan, A. Synthesis and Characterization of Al Doped ZnO (AZO) by Sol-Gel Method. IOP Conf. Ser. Mater. Sci. Eng. 2017, 176, 012049. [Google Scholar] [CrossRef]
- Achehboune, M.; Khenfouch, M.; Boukhoubza, I.; Leontie, L.; Doroftei, C.; Carlescu, A.; Bulai, G.; Mothudi, B.; Zorkani, I.; Jorio, A. Microstructural, FTIR and Raman Spectroscopic Study of Rare Earth Doped ZnO Nanostructures. Mater. Today Proc. 2022, 53, 319–323. [Google Scholar] [CrossRef]
- Adesoye, S.; Dellinger, K. ZnO and TiO2 nanostructures for surface-enhanced Raman scattering-based bio-sensing: A review. Sens. Bio-Sens. Res. 2022, 37, 100499. [Google Scholar] [CrossRef]
- Sudakar, C.; Kharel, P.; Lawes, G.; Suryanarayanan, R.; Naik, R.; Naik, V. Raman spectroscopic studies of oxygen defects in Co-doped ZnO films exhibiting room-temperature ferromagnetism. J. Phys. Condens. Matter 2007, 19, 026212. [Google Scholar] [CrossRef]
- Hieu, N.; Lien, T.; Van, T.; Juang, R. Enhanced removal of various dyes from aqueous solutions by UV and simulated solar photocatalysis over TiO2/ZnO/rGO composites. Sep. Purif. Technol. 2020, 232, 115962. [Google Scholar]
- Abdullah, K.A.; Awad, S.; Zaraket, J.; Salame, C. Synthesis of ZnO Nanopowders By Using Sol-Gel and Studying Their Structural and Electrical Properties at Different Temperature. Energy Procedia 2017, 119, 565–570. [Google Scholar] [CrossRef]
- Muhammad, W.; Ullahb, N.; Haroona, M.; Abbasi, B.H. Optical, morphological and biological analysis of zinc oxide nanocomposites (ZnO NPs) using Papaver somniferum L. RSC Adv. 2019, 9, 29541–29548. [Google Scholar] [CrossRef]
- Roguai, S.; Djelloul, A. Structural, microstructural and photocatalytic degradation of methylene blue of zinc oxide and Fe-doped ZnO nanocomposites prepared by simple coprecipitation method. Solid State Commun. 2021, 45, 334–335. [Google Scholar]
- Rataboul, F.; Nayral, C.; Casanove, M.; Maisonnat, A.; Chaudret, B. Synthesis and characterization of monodisperse zinc and zinc oxide nanocomposites from the organometallic precursor [Zn(C6H11)2]. J. Organometalic Chem. 2002, 85, 643–644. [Google Scholar]
- Rasmussen, J.; Martinez, E.; Louka, P.; Wingett, D. Zinc oxide nanocomposites for selective destruction of tumor cells and potential for drug delivery applications. Expert Opin. Drug Deliv. 2010, 7, 1063–1077. [Google Scholar] [CrossRef]
- Vandebriel, R.; De Jong, W. A review of mammalian toxicity of ZnO nanocomposites, Nanotechnology. Sci. Appl. 2012, 5, 61–71. [Google Scholar]
- Naserian, F.; Mesgar, A. Development of antibacterial and superabsorbent wound composite sponges containing carboxymethyl cellulose/gelatin/Cu-doped ZnO nanocomposites. Colloids Surf. B Biointerfaces 2022, 218, 112729. [Google Scholar] [CrossRef]
- Elmer, W.; White, J. The use of metallic oxide nanocomposites to enhance growth of tomatoes and eggplants in disease infested soil or soillessmedium. Environ. Sci. Nano 2016, 3, 1072–1079. [Google Scholar] [CrossRef]
- Mani, M.; Pavithra, S.; Mohanraj, K.; Kumaresan, S.; Alotaibi, S.S.; Eraqi, M.M.; Gandhi, A.D.; Babujanarthanam, R.; Maaza, M.; Kaviyarasu, K. Studies on the spectrometric analysis of metallic silver nanocomposites (Ag NPs) using Basella alba leaf for the antibacterial activities. Environ. Res. 2021, 199, 111274. [Google Scholar] [CrossRef] [PubMed]
- Espitia, P.; Soares, N.; Coimbra, J.; De Andrade, N.; Cruz, R.; Medeiros, E. Zinc oxide nanocomposites: Synthesis, antimicrobial activity and food packaging applications. Food Bioprocess Technol. 2012, 5, 1447–1464. [Google Scholar] [CrossRef]
- Rajkumari, J.; Magdalane, C.M.; Siddhardha, B.; Madhavan, J.; Ramalingam, G.; Al-Dhabi, N.A.; Arasu, M.V.; Ghilan, A.; Duraipandiayan, V.; Kaviyarasu, K. Synthesis of titanium oxide nanocomposites using Aloe barbadensis mill and evaluation of its antibiofilm potential against Pseudomonas aeruginosa PAO1. J. Photochem. Photobiol. B Biol. 2019, 201, 111667. [Google Scholar] [CrossRef] [PubMed]
- Parasuraman, P.; Antony, A.P.; Sharan, A.; Siddhardha, B.; Kasinathan, K.; Bahkali, N.; Dawoud, T.M.; Syed, A. Antimicrobial photodynamic activity of toluidine blue encapsulated in mesoporous silica nanocomposites against Pseudomonas aeruginosa and Staphylococcus aureus. Biofouling 2019, 35, 89–103. [Google Scholar] [CrossRef] [PubMed]
Disclaimer/Publisher’s Note: The statements, opinions and data contained in all publications are solely those of the individual author(s) and contributor(s) and not of MDPI and/or the editor(s). MDPI and/or the editor(s) disclaim responsibility for any injury to people or property resulting from any ideas, methods, instructions or products referred to in the content. |
© 2023 by the authors. Licensee MDPI, Basel, Switzerland. This article is an open access article distributed under the terms and conditions of the Creative Commons Attribution (CC BY) license (https://creativecommons.org/licenses/by/4.0/).